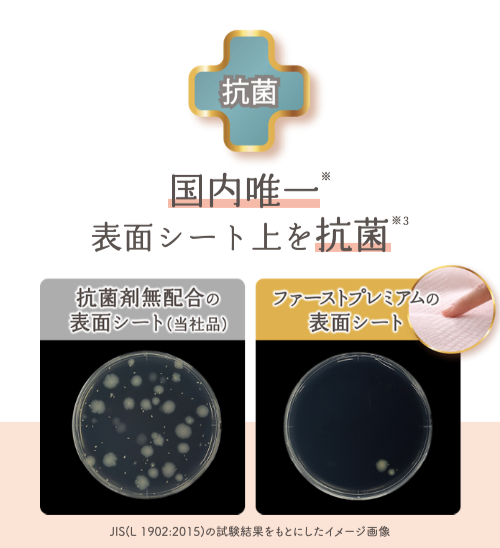

募集期間
2024/06/10 15:00 ~ 2024/08/26 23:59
終了しました
キャンペーンの詳細
【プレゼント対象商品】
■ファーストプレミアム(テープタイプ、新生児・Sサイズ、3枚1セット)
■ずっと肌さらエアスルー(パンツタイプ、S・Mサイズ、2枚1セット)
暑い季節も、ムレを追い出してず〜〜っと肌さら!
『メリーズファーストプレミアム テープタイプ』『メリーズずっと肌さらエアスルー パンツタイプ』のサンプルを、どど~んとプレゼント!
◆メリーズファーストプレミアム◆

おむつは赤ちゃんの肌に触れるものだから、やさしく、長時間快適なおむつを選んであげたい……
メリーズファーストプレミアムは、国内唯一※、表面シート上を抗菌※3。
おむつ内環境をより清潔に保ちます。

※子供用紙おむつにおいて。Mintel社データベース、及び別情報を用いた花王調べ(23年2月)。
※3 肌表面を抗菌するものではありません。全ての細菌の増殖を抑制するものではありません。


夏場のデリケートな赤ちゃんのお肌も健やかに。
はじめての夏を過ごす赤ちゃんにおすすめです。
◆メリーズずっと肌さらエアスルー◆

50億個以上※の目に見えない穴で、おむつの外側に湿気をスル〜ッ。
おしっこ後もまるでつけたての状態に!
※走査電子顕微鏡画像から判定 おむつ1枚あたりに換算



ふんわりやわらかな凸凹シートが、ゆるゆるうんちも広げずキャッチ!
凸凹が空気の通り道になり、スーッとムレを追い出します。
赤ちゃんのお肌が気になる暑い季節に!
ずっと肌さらさら『メリーズ ファーストプレミアム』『メリーズ ずっと肌さらエアスルー』をぜひおためしください♪
【キャンペーン概要】
「メリーズファーストプレミアム テープタイプ」または「メリーズ ずっと肌さらエアスルー パンツタイプ」を、抽選で18万枚プレゼントいたします!
■プレゼント内容
・メリーズ ファーストプレミアム テープタイプ(新生児・S)サンプル3枚1セット
・メリーズ ずっと肌さらエアスルー パンツタイプ(S・M)サンプル2枚1セット
※上記サンプルのいずれか1つをお選びください。
■当選数
合計18万枚
【ファーストプレミアム テープタイプ】12万枚
【さらさらエアスルー パンツタイプ】6万枚
■応募期間
2024/06/10 15:00 ~ 2024/08/30 23:59
[PR]花王
※本キャンペーンは、花王が主催するキャンペーンです。
※応募ボタンを押すと、花王のキャンペーンサイトへ移動します。
※キャンペーンの内容についてのご質問は、コズレマガジンにお問い合わせいただいた場合お答えできかねます。主催企業にお問い合わせください。
■ファーストプレミアム(テープタイプ、新生児・Sサイズ、3枚1セット)
■ずっと肌さらエアスルー(パンツタイプ、S・Mサイズ、2枚1セット)
『メリーズファーストプレミアム テープタイプ』『メリーズずっと肌さらエアスルー パンツタイプ』のサンプルを、どど~んとプレゼント!
◆メリーズファーストプレミアム◆

おむつは赤ちゃんの肌に触れるものだから、やさしく、長時間快適なおむつを選んであげたい……
メリーズファーストプレミアムは、国内唯一※、表面シート上を抗菌※3。
おむつ内環境をより清潔に保ちます。
※子供用紙おむつにおいて。Mintel社データベース、及び別情報を用いた花王調べ(23年2月)。
※3 肌表面を抗菌するものではありません。全ての細菌の増殖を抑制するものではありません。


夏場のデリケートな赤ちゃんのお肌も健やかに。
はじめての夏を過ごす赤ちゃんにおすすめです。
◆メリーズずっと肌さらエアスルー◆

50億個以上※の目に見えない穴で、おむつの外側に湿気をスル〜ッ。
おしっこ後もまるでつけたての状態に!
※走査電子顕微鏡画像から判定 おむつ1枚あたりに換算



ふんわりやわらかな凸凹シートが、ゆるゆるうんちも広げずキャッチ!
凸凹が空気の通り道になり、スーッとムレを追い出します。
赤ちゃんのお肌が気になる暑い季節に!
ずっと肌さらさら『メリーズ ファーストプレミアム』『メリーズ ずっと肌さらエアスルー』をぜひおためしください♪
【キャンペーン概要】
「メリーズファーストプレミアム テープタイプ」または「メリーズ ずっと肌さらエアスルー パンツタイプ」を、抽選で18万枚プレゼントいたします!
■プレゼント内容
・メリーズ ファーストプレミアム テープタイプ(新生児・S)サンプル3枚1セット
・メリーズ ずっと肌さらエアスルー パンツタイプ(S・M)サンプル2枚1セット
※上記サンプルのいずれか1つをお選びください。
■当選数
合計18万枚
【ファーストプレミアム テープタイプ】12万枚
【さらさらエアスルー パンツタイプ】6万枚
■応募期間
2024/06/10 15:00 ~ 2024/08/30 23:59
[PR]花王
※本キャンペーンは、花王が主催するキャンペーンです。
※応募ボタンを押すと、花王のキャンペーンサイトへ移動します。
※キャンペーンの内容についてのご質問は、コズレマガジンにお問い合わせいただいた場合お答えできかねます。主催企業にお問い合わせください。
終了しました
注意事項
■本キャンペーンはコズレとは主催企業が異なります。通常のプレゼントキャンペーンとは異なり、応募完了をお知らせするメールが配信されません。あらかじめご承知おき下さい。
■主催者の事情でキャンペーン内容が予告なく変更された場合、本ページの内容が実際のキャンペーンと異なることがございます。あらかじめご了承ください。
■コズレにおける本キャンペーンの告知期間は、リンク先のキャンペーン開催期間と異なる場合がございますのであらかじめご了承ください。
■ご紹介したプレゼントのデザイン・内容等は変わることがあります。
■メールでコズレの新規会員登録される方は、ドメイン指定受信を設定している場合は「@cozre.jp」「@cozre.co.jp」からの受信を許可してください。
■ネット接続料はお客様自身のご負担になります。
■応募ボタンを押すと、花王のキャンペーンサイトへ移動します。
■主催者の事情でキャンペーン内容が予告なく変更された場合、本ページの内容が実際のキャンペーンと異なることがございます。あらかじめご了承ください。
■コズレにおける本キャンペーンの告知期間は、リンク先のキャンペーン開催期間と異なる場合がございますのであらかじめご了承ください。
■ご紹介したプレゼントのデザイン・内容等は変わることがあります。
■メールでコズレの新規会員登録される方は、ドメイン指定受信を設定している場合は「@cozre.jp」「@cozre.co.jp」からの受信を許可してください。
■ネット接続料はお客様自身のご負担になります。
■応募ボタンを押すと、花王のキャンペーンサイトへ移動します。
終了しました